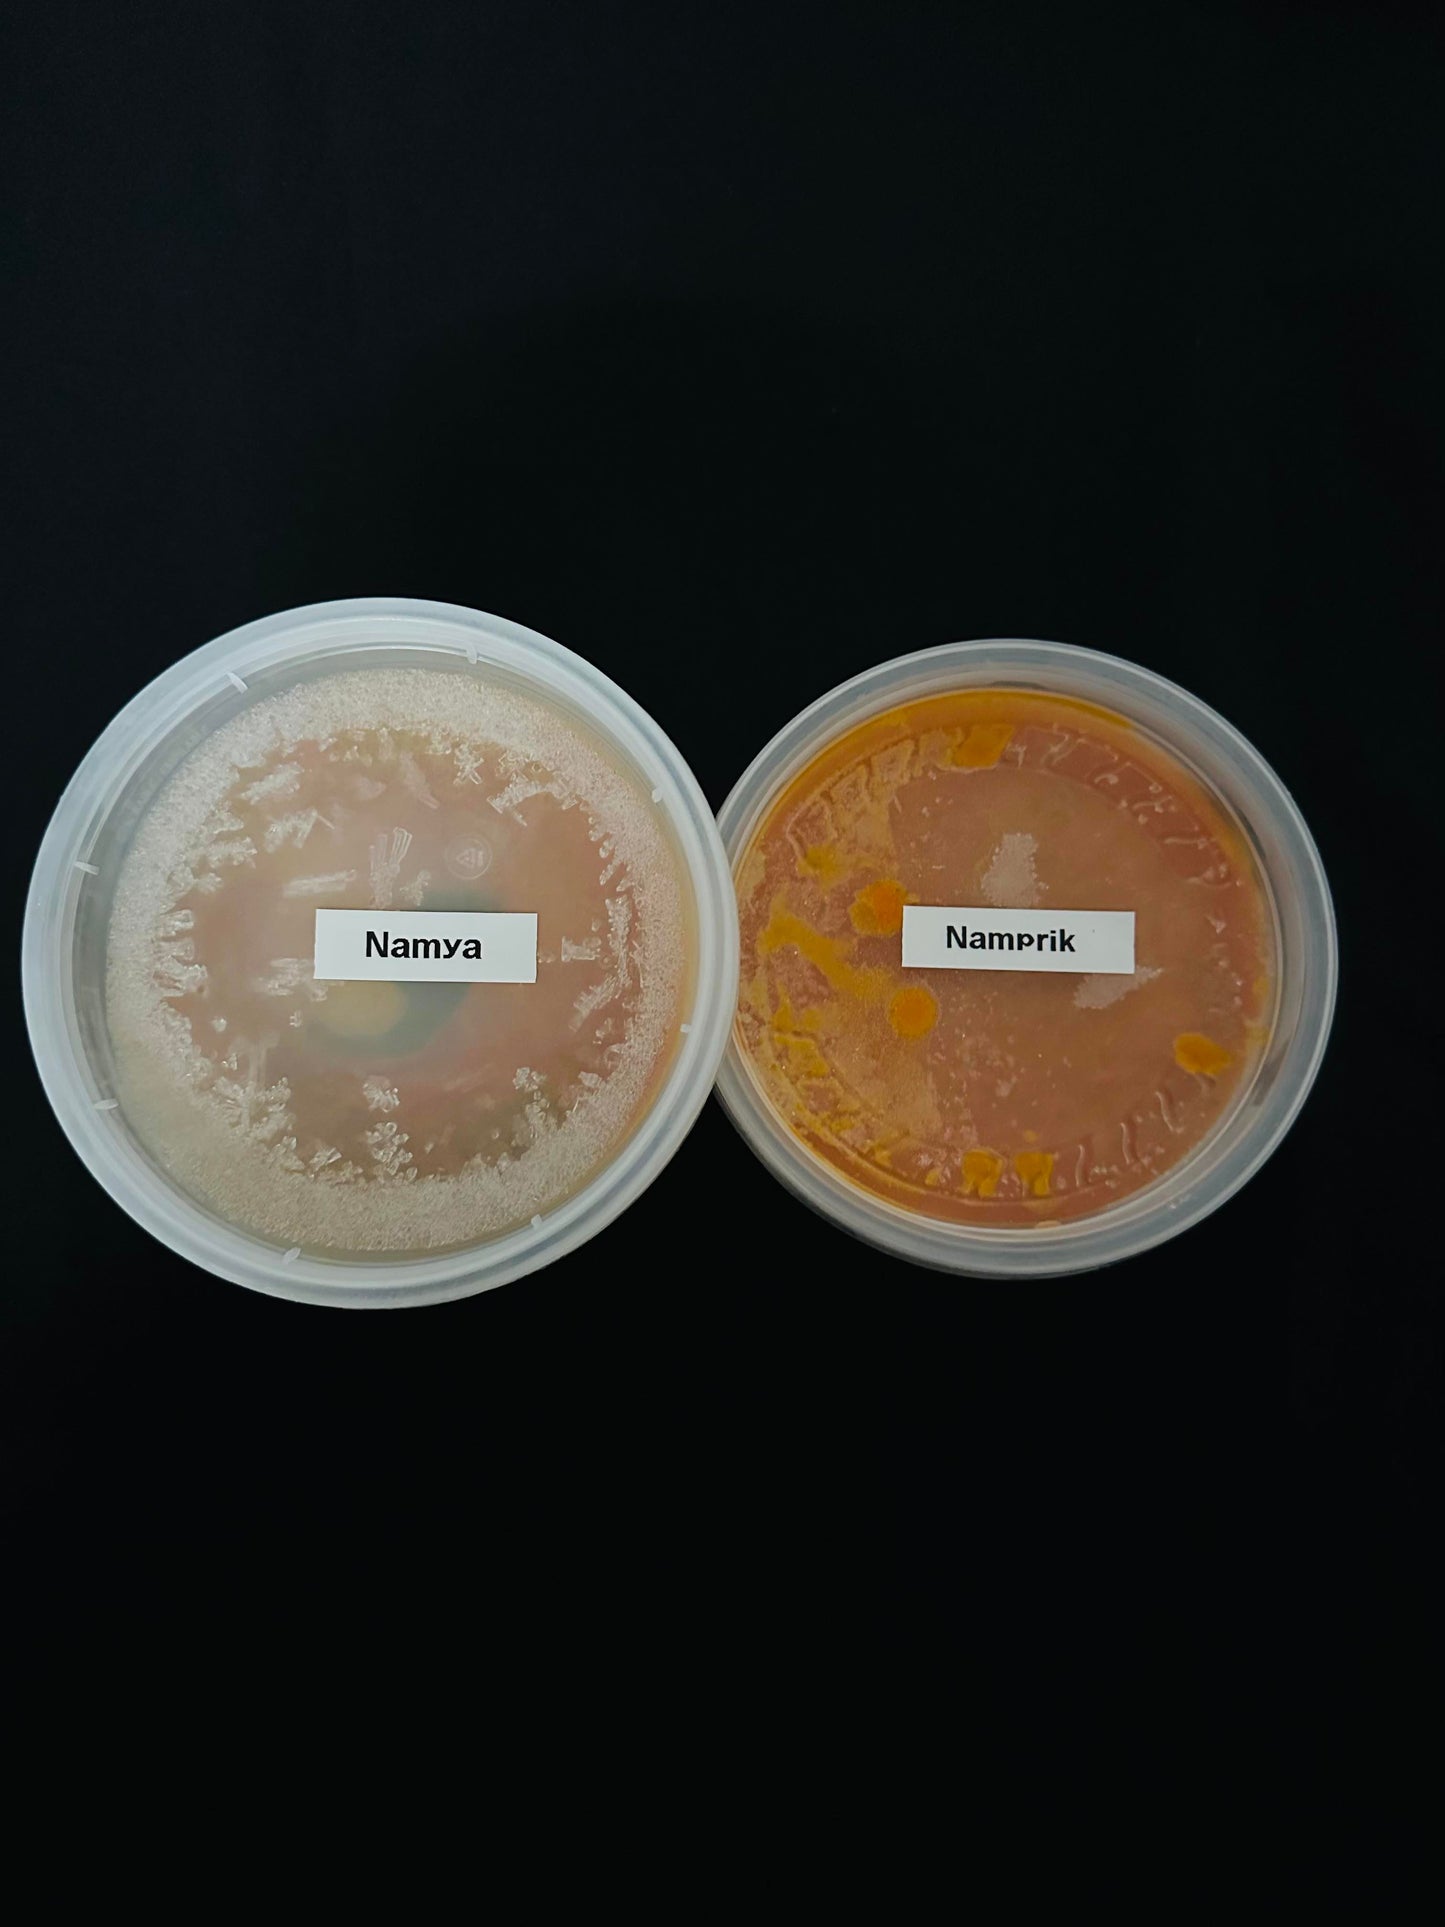
Nam-prik & Nam-ya (per set) 🌶️

Roynee
Nam-prik & Nam-ya (per set) 🌶️
Nam-prik & Nam-ya (per set) 🌶️
Couldn't load pickup availability
Nam Prik and Nam Ya are versatile Thai condiments commonly enjoyed with Kanom Jeen, a type of Thai rice noodle. Here's a brief explanation of each and how they are typically consumed:
-
Nam Prik: Nam Prik, as mentioned earlier, refers to a range of Thai chili-based dips or sauces. These dips are often served alongside Kanom Jeen. They are typically made with pounded chilies, garlic, shallots, fish sauce, lime juice, and other ingredients, resulting in a flavorful and spicy sauce. When eating Kanom Jeen, you can spoon some Nam Prik onto your plate and then mix it with the rice noodles. This allows you to control the level of spiciness and flavor to suit your preference. You can also pair Nam Prik with various fresh herbs, vegetables, and side dishes to enhance the taste.
-
Nam Ya (Kanom Jeen): Nam Ya, in the context of Kanom Jeen, refers to a fish-based curry sauce that is specifically served with Kanom Jeen rice noodles. The Nam Ya sauce is typically made with fish or shrimp, coconut milk, herbs, and spices, resulting in a rich and aromatic curry. To enjoy Nam Ya with Kanom Jeen, pour the sauce over the rice noodles and mix them together. The noodles will absorb the flavors of the curry, creating a delicious combination. You can also top it with fresh herbs, vegetables, and condiments like sliced cucumbers, bean sprouts, and fried shallots to add texture and additional flavors.
When consuming Kanom Jeen with Nam Prik or Nam Ya, feel free to customize your dish according to your taste preferences. You can adjust the amount of sauce, spiciness, and additional toppings to create a delightful and satisfying meal.
Spicy level
Nam prik: 0/4
Nam ya: 2/4
Format: Frozen, 2x250ml, rice or noodle not included!